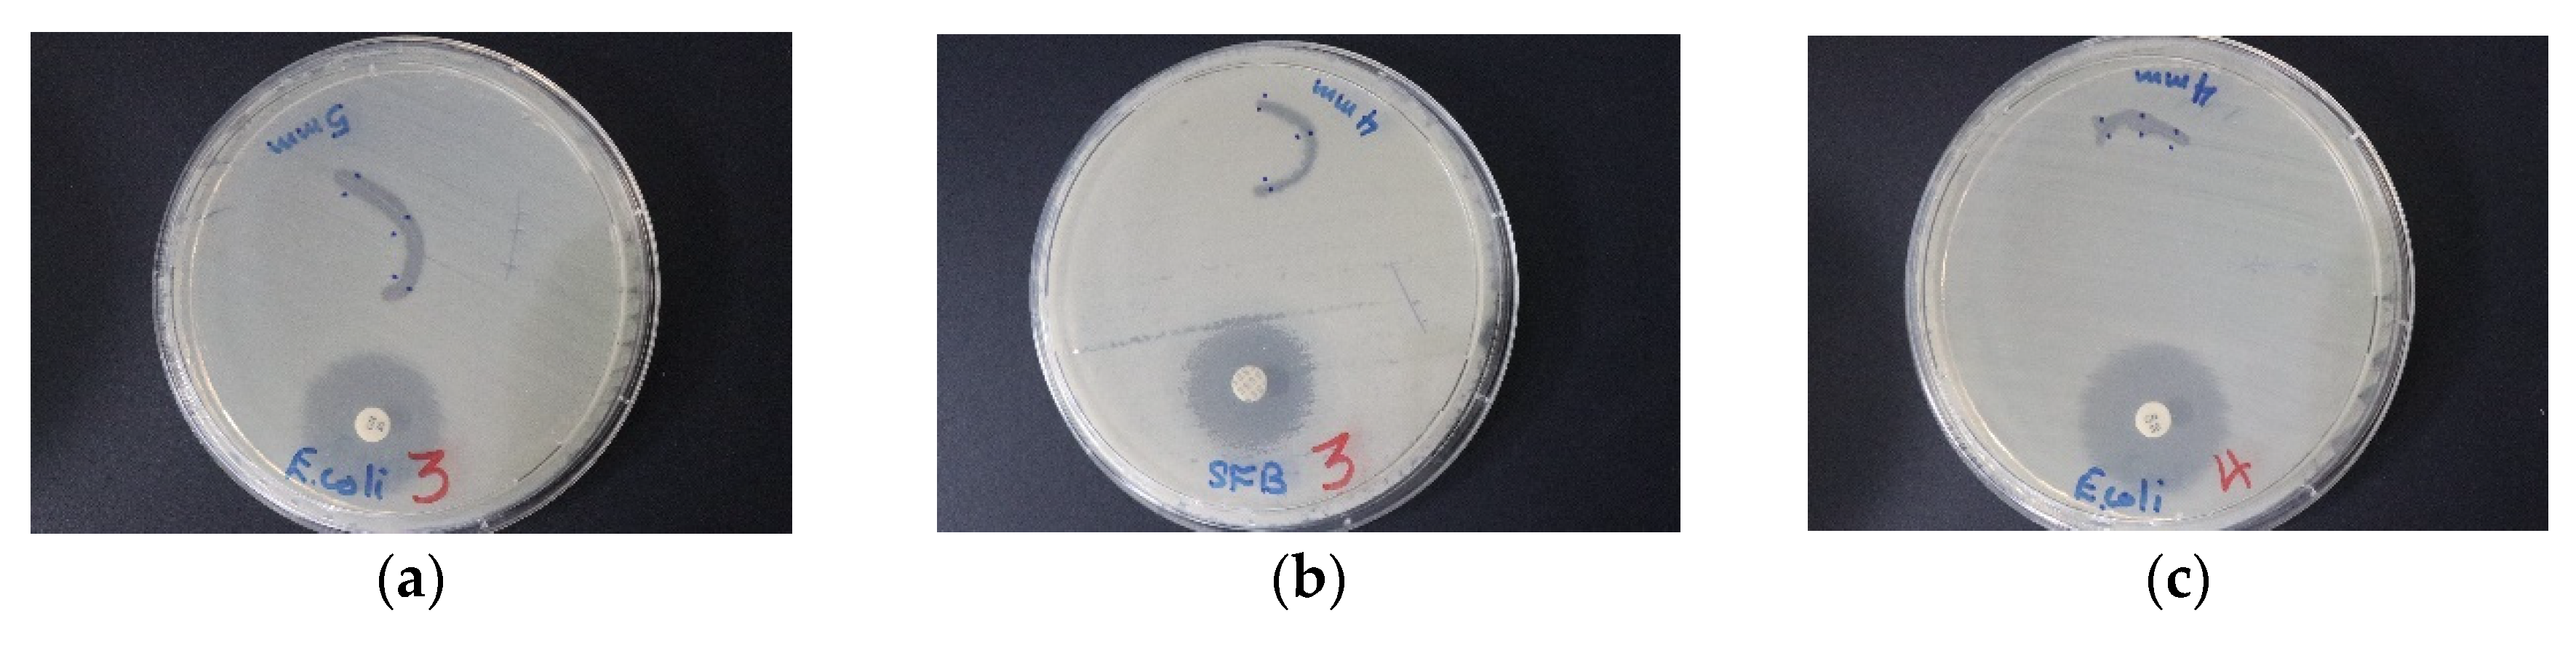
Pharmaceutics 12 00361 g014

“Smart” Antimicrobial Nanocomplexes with Potential to Decrease Surgical Site Infections (SSI)
Abstract
1. Introduction
2. Materials and Methods
2.1. Materials
2.2. Preparation of Silver Nanoparticles with Trans-Cinnamic Acid (TCA) as Capping Agent (TCA-AgNP)
2.3. Preparation of Silver Nanoparticles with Cinnamon Bark Extract as Capping Agent (Cinn-AgNPs)
2.3.1. Preparation of Cinnamomum zeylanicum (Cinn) Bark Extract
2.3.2. Phytosynthesis of Nano-Scale Ag Particles (Cinn-AgNP)
2.4. Synthesis of Povidone Iodine (PI) Capped Silver Nanoparticles (TCA-AgNP-PI and Cinn-AgNP-PI)
2.5. Characterizations of Synthesized AgNP Samples
2.5.1. Morphological Examination and Particle-Size Measurement
2.5.2. Size and Zeta-Potential Analysis
2.5.3. UV-Vis Spectrophotometry
2.5.4. Fourier-Transform Infrared Spectroscopy
2.5.5. X-Ray Diffraction (XRD) Analysis of AgNPs
2.5.6. Characterization by Surface-Enhanced Raman Spectroscopy (SERS)
2.6. Bacterial Strains and Culturing
2.7. Investigation/Determination of Antibacterial and Antifungal Properties of TCA-AgNP, TCA-AgNP-PI, Cinn-AgNP, and Cinn-AgNP-PI
2.7.1. Procedure for Zone of Inhibition Plate Studies
2.7.2. Agar Well Diffusion Method
2.7.3. Disc Diffusion Method
2.8. Preparation of Sutures Coated with AgNPs Samples, Dip-Coating, and Characterization
2.9. Statistical Analysis
3. Results
3.1. Morphological Examination and Particle-Size Measurement
SEM and EDS Analysis
3.2. Particle Size, PDL, and Zeta Potential of TCA-AgNP, TCA-AgNP-PI, Cinn-AgNP, and Cinn-AgNP-PI
3.2.1. Dynamic Light Scattering (DLS)
3.2.2. Zeta Potential Analysis
3.3. UV-Vis Spectroscopic Analysis of TCA-AgNP, TCA-AgNP-PI, Cinn-AgNP, and Cinn-AgNP-PI
3.4. FT-IR Spectroscopic Analysis of TCA-AgNP, TCA-AgNP-PI, Cinn-AgNP, and Cinn-AgNP-PI
3.5. X-Ray Diffraction Measurement of TCA-AgNP, TCA-AgNP-PI, Cinn-AgNP, and Cinn-AgNP-PI
3.6. SERS Analysis of TCA-AgNP, TCA-AgNP-PI, Cinn-AgNP, and Cinn-AgNP-PI
3.7. Antimicrobial Activities of TCA-AgNP, TCA-AgNP-PI, Cinn-AgNP, and Cinn-AgNP-PI
3.7.1. Determination of Antimicrobial Properties of TCA-AgNP, TCA-AgNP-PI, Cinn-AgNP, and Cinn-AgNP-PI
3.7.2. Determination of Antimicrobial Properties of Sutures Dip-Coated with TCA-AgNP, TCA-AgNP-PI, Cinn-AgNP, and Cinn-AgNP-PI
4. Discussion
5. Conclusions
Supplementary Materials
Author Contributions
Funding
Acknowledgments
Conflicts of Interest
References
- Shrivastava, S.; Shrivastava, P.; Ramasamy, J. World health organization releases global priority list of antibiotic-resistant bacteria to guide research, discovery, and development of new antibiotics. J. Med. Soc. 2018, 32, 76–77. [Google Scholar] [CrossRef]
- Chokshi, A.; Sifri, Z.; Cennimo, D.; Horng, H. Global Contributors to Antibiotic Resistance. J. Glob. Infect. Dis. 2019, 11, 36–42. [Google Scholar] [CrossRef]
- Mulani, M.S.; Kamble, E.E.; Kumkar, S.N.; Tawre, M.S.; Pardesi, K.R. Emerging Strategies to Combat ESKAPE Pathogens in the Era of Antimicrobial Resistance: A Review. Front. Microbiol. 2019, 10, 539–563. [Google Scholar] [CrossRef] [PubMed]
- Kamaruzzaman, N.; Pina, M.; Chivu, A.; Good, L. Polyhexamethylene biguanide and nadifloxacin self-assembled nanoparticles: Antimicrobial effects against intracellular methicillin-resistant Staphylococcus aureus. Polymers 2018, 10, 521. [Google Scholar] [CrossRef] [PubMed]
- Kamaruzzaman, N.F.; Tan, L.P.; Hamdan, R.H.; Choong, S.S.; Wong, W.K.; Gibson, A.J.; Chivu, A.; Pina, M.F. Antimicrobial Polymers: The Potential Replacement of Existing Antibiotics? Int. J. Mol. Sci. 2019, 20, 2747. [Google Scholar] [CrossRef] [PubMed]
- Yu, Z.; Tang, J.; Khare, T.; Kumar, V. The alarming antimicrobial resistance in ESKAPEE pathogens: Can essential oils come to the rescue? Fitoterapia 2020, 40, 104433. [Google Scholar] [CrossRef]
- Cassini, A.; Hogberg, L.D.; Plachouras, D.; Quattrocchi, A.; Hoxha, A.; Simonsen, G.S.; Colomb-Cotinat, M.; Kretzschmar, M.E.; Devleesschauwer, B.; Cecchini, M.; et al. Attributable deaths and disability-adjusted life-years caused by infections with antibiotic-resistant bacteria in the EU and the European Economic Area in 2015: A population-level modelling analysis. Lancet Infect. Dis. 2019, 19, 56–66. [Google Scholar] [CrossRef]
- Touat, M.; Opatowski, M.; Brun-Buisson, C.; Cosker, K.; Guillemot, D.; Salomon, J.; Tuppin, P.; de Lagasnerie, G.; Watier, L. A payer perspective of the hospital inpatient additional care costs of antimicrobial resistance in France: A matched case–control study. Appl. Health Econ. Health Policy 2019, 17, 381–389. [Google Scholar] [CrossRef]
- European Comission. EU Action on Antimicrobial Resistance. ECDC: Surveillance of Antimicrobial Resistance in Europe 2018. Available online: https://www.ecdc.europa.eu/sites/default/files/documents/surveillance-antimicrobial-resistance-Europe-2018 (accessed on 9 February 2020).
- Shanmugaraj, B.; Malla, A.; Phoolcharoen, W. Emergence of Novel Coronavirus 2019-nCoV: Need for Rapid Vaccine and Biologics Development. Pathogens 2020, 9, 148. [Google Scholar] [CrossRef]
- Kourtis, A.P.; Hatfield, K.; Baggs, J.; Mu, Y.; See, I.; Epson, E.; Nadle, J.; Kainer, M.A.; Dumyati, G.; Petit, S. Vital Signs: Epidemiology and Recent Trends in Methicillin-Resistant and in Methicillin-Susceptible Staphylococcus aureus Bloodstream Infections—United States. Morb. Mortal. Wkly. Rep. 2019, 68, 214. [Google Scholar] [CrossRef]
- Mir, M.; Ahmed, N.; Permana, A.D.; Rodgers, A.M.; Donnelly, R.F.; Rehman, A. Enhancement in Site-Specific Delivery of Carvacrol against Methicillin Resistant Staphylococcus aureus Induced Skin Infections Using Enzyme Responsive Nanoparticles: A Proof of Concept Study. Pharmaceutics 2019, 11, 606. [Google Scholar] [CrossRef] [PubMed]
- Konai, M.M.; Bhattacharjee, B.; Ghosh, S.; Haldar, J. Recent Progress in Polymer Research to Tackle Infections and Antimicrobial Resistance. Biomacromolecules 2018, 19, 1888–1917. [Google Scholar] [CrossRef] [PubMed]
- Francolini, I.; Piozzi, A. Polymeric Systems as Antimicrobial or Antifouling Agents. Int. J. Mol. Sci. 2019, 20, 4866. [Google Scholar] [CrossRef] [PubMed]
- Eleraky, N.E.; Allam, A.; Hassan, S.B.; Omar, M.M. Nanomedicine Fight against Antibacterial Resistance: An Overview of the Recent Pharmaceutical Innovations. Pharmaceutics 2020, 12, 142. [Google Scholar] [CrossRef]
- Villegas, N.A.; Ravetti, S.; Bermu’dez, J.M.; Cid, A.G.; Allemandi, D.A.; Palma, S.D. Metallic nanoparticles as a strategy for the treatment of infectious diseases. In Materials for Biomedical Engineering: Bioactive Materials for Antimicrobial, Anticancer, and Gene Therapy, 1st ed.; Holban, A.M., Grumezescu, A.M., Eds.; Elsevier Inc.: Amsterdam, The Netherlands, 2019; Chapter 14; pp. 383–407. [Google Scholar]
- Eming, S.A.; Martin, P.; Tomic-Canic, M. Wound repair and regeneration: Mechanisms, signaling, and translation. Sci. Transl. Med. 2014, 6, 265sr6. [Google Scholar] [CrossRef]
- Lindley, L.E.; Stojadinovic, O.; Pastar, I.; Tomic-Canic, M. Biology and Biomarkers for Wound Healing. Plast. Reconstr. Surg. 2016, 138, 18S–28S. [Google Scholar] [CrossRef]
- Hamdan, S.; Pastar, I.; Drakulich, S.; Dikici, E.; Tomic-Canic, M.; Deo, S.; Daunert, S. Nanotechnology-Driven Therapeutic Interventions in Wound Healing: Potential Uses and Applications. Cent. Sci. 2017, 3, 163–175. [Google Scholar] [CrossRef]
- Kalan, L.; Grice, E.A. Fungi in the Wound Microbiome. Adv. Wound Care 2018, 7, 247–255. [Google Scholar] [CrossRef]
- Maccelli, A.; Vitanza, L.; Imbriano, A.; Fraschetti, C.; Filippi, A.; Goldoni, P.; Maurizi, L.; Ammendolia, M.G.; Crestoni, M.E.; Fornarini, S.; et al. Satureja montana L. Essential Oils: Chemical Profiles/Phytochemical Screening, Antimicrobial Activity and O/WNanoEmulsion Formulations. Pharmaceutics 2020, 12, 7. [Google Scholar] [CrossRef]
- Silva, L.N.; Zimmer, K.R.; Macedo, A.J.; Trentin, D.S. Plant Natural Products Targeting Bacterial Virulence Factors. Chem. Rev. 2016, 116, 9162–9236. [Google Scholar] [CrossRef]
- Baygar, T.; Sarac, N.; Ugur, A.; Karaca, I.R. Antimicrobial characteristics and biocompatibility of the surgical sutures coated with biosynthesized silver nanoparticles. Bioorganic Chem. 2019, 86, 254–258. [Google Scholar] [CrossRef] [PubMed]
- Gallo, A.L.; Paladini, F.; Romano, A.; Verri, T.; Quattrini, A.; Sannino, A.; Pollini, M. Efficacy of silver coated surgical sutures on bacterial contamination, cellular response and wound healing. Mat. Sci. Eng. 2016, 69, 884–893. [Google Scholar] [CrossRef] [PubMed]
- Joseph, B.; George, A.; Gopi, S.; Kalarikkal, N.; Thomas, S. Polymer sutures for simultaneous wound healing and drug delivery—A review. Int. J. Pharmac. 2017, 524, 454–466. [Google Scholar] [CrossRef] [PubMed]
- Vasudevan, P.; Tandon, M. Antimicrobial properties of iodine based products. J. Sci. Ind. Res. 2010, 69, 376–383. [Google Scholar]
- Kaiho, T. Iodine Chemistry and Applications, 1st ed.; Kaiho, T., Ed.; John Wiley & Sons, Inc.: Hoboken, NJ, USA, 2015; pp. 15–410, ISBN-13 978-1-118-46629-2. [Google Scholar]
- He, C.; Parrish, D.A.; Shreeve, J.M. Alkyl ammonium cation stabilized biocidal polyiodides with adaptable high density and low pressure. Chem. Eur. J. 2014, 20, 6699–6706. [Google Scholar] [CrossRef] [PubMed]
- Zhao, G.; He, C.; Zhou, W.; Hooper, J.P.; Imler, G.H.; Parrish, D.A.; Shreeve, J.M. Control of Biohazards: A High Performance Energetic Polycyclized Iodine-Containing Biocide. Inorg. Chem. 2018, 57, 8673–8680. [Google Scholar] [CrossRef]
- Manchanda, G.; Sodhi, R.K.; Jain, U.K.; Chandra, R.; Madan, J. Iodinated curcumin bearing dermal cream augmented drug delivery, antimicrobial and antioxidant activities. J. Microencapsul. 2018, 35, 49–61. [Google Scholar] [CrossRef]
- Viswanathan, K.; Babu, D.B.; Jayakumar, G.; Raj, G.D. Anti-microbial and skin wound dressing application of molecular iodine nanoparticles. Mater. Res. Express 2017, 4, 104003. [Google Scholar] [CrossRef]
- Bigliardi, P.L.; Alsagoff, S.A.L.; El-Kafrawi, H.Y.; Pyon, J.-K.; Wa, C.T.C.; Villa, M.A. Povidone iodine in wound healing: A review of current concepts and practices. Int. J. Surg. 2017, 44, 260–268. [Google Scholar] [CrossRef]
- Svensson, P.H.; Kloo, L. Synthesis, structure, and bonding in polyiodide and metal iodide−iodine systems. Chem. Rev. 2003, 103, 1649–1684. [Google Scholar] [CrossRef]
- Blake, A.J.; Li, W.S.; Lippolis, V.; Schröder, M.; Devillanova, F.A.; Gould, R.O.; Parsons, S.; Radek, C. Template self-assembly of polyiodide networks. Chem. Soc. Rev. 1998, 27, 195–206. [Google Scholar] [CrossRef]
- Edis, Z.; Bloukh, S.H. Preparation and structural and spectroscopic characterization of a pentaiodide [Rb(12-crown-4)2]I5. Z. Nat. 2013, 68, 1340–1346. [Google Scholar]
- Van Mengen, M.; Reiss, G.J. I62− Anion composed of two asymmetric triiodide moieties: A competition between halogen and hydrogen bond. Inorganics 2013, 1, 3–13. [Google Scholar] [CrossRef]
- Reiss, G.J. Halogen and hydrogen bonding in the layered crystal structure of 2-iodoaniliniumtriiodide, C6H7I4N. Z. Kristallogr. NCS 2019, 234, 899–902. [Google Scholar]
- Wen, X.; Zhang, X.; Szewczyk, G.; El-Hussein, A.; Huang, Y.-Y.; Sarna, T.; Hamblin, M.R. Potassium iodide potentiates antimicrobial photodynamic inactivation mediated by rose bengal in in vitro and in vivo studies. Antimicrob. Agents Chemother. 2017, 61, e00467-17. [Google Scholar] [CrossRef]
- Vieira, C.; Gomes, A.T.P.C.; Mesquita, M.Q.; Moura, N.M.M.; Neves, M.G.P.M.S.; Faustino, M.A.F.; Almeida, A. An Insight into the Potentiation Effect of Potassium Iodide on aPDT Efficacy. Front. Microbiol. 2018, 9, 2665. [Google Scholar] [CrossRef] [PubMed]
- Bartashevich, E.V.; Grigoreva, E.A.; Yushina, I.D.; Bulatova, L.M.; Tsirelson, V.G. Modern level for the prediction of properties of iodine-containing organic compounds: Iodine forming halogen bonds. Russ. Chem. Bull. Int. Ed. 2017, 66, 1–12. [Google Scholar] [CrossRef]
- Edis, Z.; Bloukh, S.H. Preparation and structural and spectroscopic characterization of triiodides [M(12-crown-4)2]I3 with M = Na and Rb. Z. Nat. 2014, 69, 995–1002. [Google Scholar]
- Edis, Z.; Haj Bloukh, S.; Abu Sara, H.; Bhakhoa, H.; Rhyman, L.; Ramasami, P. “Smart” triiodide compounds: Does halogen bonding influence antimicrobial activities? Pathogens 2019, 8, 182. [Google Scholar] [CrossRef]
- Haj Bloukh, S.; Edis, Z. Halogen bonding in Crystal structure of bis(1,4,7,10-tetraoxacyclododecane-κ4O,O′,O′′,O′′′)cesium triiodide, C16H32CsI3O8. Z. Kristallogr. NCS 2020, in press. [Google Scholar] [CrossRef]
- Haj Bloukh, S.; Edis, Z. Structure and Antimicrobial properties of bis(1,4,7,10-tetraoxacyclododecane-κ4O,O′,O′′,O′′′)cesium pentaiodide, C16H32CsI5O8. Z. Kristallogr. NCS 2020, in press. [Google Scholar] [CrossRef]
- Arora, S.; Yadav, V.; Kumar, P.; Gupta, R.; Kumar, D. Polymer based antimicrobial coatings as potential biomaterial: A review. Int. J. Pharm. Sci. Rev. Res. 2013, 23, 279–290. [Google Scholar]
- Danilovas, P.P.; Rutkaite, R.; Zemaitaitis, A. Thermal degradation and stability of cationic starches and their complexes with iodine. Carbohydr. Polym. 2014, 112, 721–728. [Google Scholar] [CrossRef]
- Some, S.; Sohn, J.S.; Kim, J.; Lee, S.-H.; Lee, S.C.; Lee, J.; Shackery, I.; Kim, S.K.; Kim, S.H.; Choi, N.; et al. Graphene-Iodine Nanocomposites: Highly Potent Bacterial Inhibitors that are Bio-compatible with Human Cells. Sci. Rep. 2015, 6, 20015. [Google Scholar] [CrossRef]
- Gao, T.; Fan, H.; Wang, X.; Gao, Y.; Liu, W.; Chen, W.; Dong, A.; Wang, Y.J. Povidone-Iodine-Based Polymeric Nanoparticles for Antibacterial applications. ACS Appl. Mater. Interfaces 2017, 9, 25738–25746. [Google Scholar] [CrossRef]
- Schmitz, G.; Rosenblatt, L.; Salerno, N.; Odette, J.; Ren, R.; Emanuel, T.; Michalek, J.; Liu, Q.; Du, L.; Jahangir, K.; et al. Treatment data using a topical povidone-iodine antiseptic in patients with superficial skin abscesses. Data Brief 2019, 23, 103715. [Google Scholar] [CrossRef]
- Goodwin, M.J.; Steed, B.W.; Yufit, D.S.; Musa, O.M.; Berry, D.J.; Steed, J.W. Halogen and Hydrogen Bonding in Povidone-Iodine and Related Co-Phases. Cryst. Growth Des. 2017, 17, 5552–5558. [Google Scholar] [CrossRef]
- Mamatha, G.; Rajulu, A.V.; Madhukar, K. Development and analysis of cellulose nanocomposite films with in situ generated silver nanoparticles using tamarind nut powder as a reducing agent. Int. J. Polymer. A Charact. 2019, 24, 219–226. [Google Scholar] [CrossRef]
- Edis, Z.; Haj Bloukh, S.; Ashames, A.; Ibrahim, M. Copper-Based Nanoparticles, their chemistry and Antibacterial properties: A Review. In Chemistry for a Clean and Healthy Planet, 1st ed.; Ramasami, P., Gupta Bhowon, M., Jhaumeer Laulloo, S., Li Kam Wah, H., Eds.; Springer Nature AG: Cham, Switzerland, 2019; pp. 401–428, ISBN-13 978-3-030-20282-8. [Google Scholar]
- Reda, M.; Ashames, A.; Edis, Z.; Bloukh, S.; Bhandare, R.; Abu Sara, H. Green Synthesis of Potent Antimicrobial Silver Nanoparticles Using Different Plant Extracts and Their Mixtures. Processes 2019, 7, 510. [Google Scholar] [CrossRef]
- Su-Eon Jin, S.-E.; Jin, H.-E. Synthesis, Characterization, and Three-Dimensional Structure Generation of Zinc Oxide-Based Nanomedicine for Biomedical Applications. Pharmaceutics 2019, 11, 575. [Google Scholar] [CrossRef]
- Shah, A.; Buabeid, M.A.; Arafa, E.A.; Hussain, I.; Lid, L.; Murtaza, G. The wound healing and antibacterial potential of triple-component nanocomposite (chitosan-silver-sericin) films loaded with moxifloxacin. Int. J. Pharm. 2019, 564, 22–38. [Google Scholar] [CrossRef] [PubMed]
- Shah, A.; Ashames, A.A.; Buabeid, M.A.; Murtaza, G. Synthesis, in vitro characterization and antibacterial efficacy of moxifloxacin-loaded chitosan-pullulan-silver-nanocomposite films. J. Drug Delivery Sci. Tech. 2020, 55, 101366–101383. [Google Scholar] [CrossRef]
- Kanwar, R.; Rathee, J.; Salunke, D.B.; Mehta, S.K. Green Nanotechnology-Driven Drug Delivery Assemblies. ACS Omega 2019, 4, 8804–8815. [Google Scholar] [CrossRef]
- Riau, A.K.; Aung, T.T.; Setiawan, M.; Yang, L.; Yam, G.H.F.; Beuerman, R.W.; Venkatraman, S.S.; Mehta, J.S. Surface Immobilization of Nano-Silver on Polymeric Medical Devices to Prevent Bacterial Biofilm Formation. Pathogens 2019, 8, 93. [Google Scholar] [CrossRef]
- Sang Hun Lee, S.H.; Jun, B.-H. Silver Nanoparticles: Synthesis and Application for Nanomedicine. Int. J. Mol. Sci. 2019, 20, 865. [Google Scholar] [CrossRef]
- Liao, C.; Li, Y.; Tjong, S.C. Bactericidal and Cytotoxic Properties of Silver Nanoparticles. Int. J. Mol. Sci. 2019, 20, 449. [Google Scholar] [CrossRef]
- Anand, U.; Jacobo-Herrera, N.; Altemimi, A.; Lakhssassi, N. A Comprehensive Review on Medicinal Plants as Antimicrobial Therapeutics: Potential Avenues of Biocompatible Drug Discovery. Metabolites 2019, 9, 258. [Google Scholar] [CrossRef]
- Burlacu, E.; Tanase, C.; Coman, N.-A.; Berta, L. A Review of Bark-Extract-Mediated Green Synthesis of Metallic Nanoparticles and Their Applications. Molecules 2019, 24, 4354. [Google Scholar] [CrossRef]
- Doyle, A.A.; Stephens, J.C. A review of cinnamaldehyde and its derivatives as antibacterial agents. Fitoterapia 2019, 139, 104405. [Google Scholar] [CrossRef]
- Premkumar, J.; Sudhakar, T.; Dhakal, A.; Shrestha, J.B.; Krishnakumar, S.; Balashanmugam, P. Synthesis of silver nanoparticles (AgNPs) from cinnamon against bacterial Pathogens. Biocat. Agric. Biotech. 2018, 15, 311–316. [Google Scholar] [CrossRef]
- Ranasinghe, P.; Pigera, S.; Premakumara, G.A.S.; Galappaththy, P.; Constantine, G.R.; Katulanda, P. Medicinal properties of ‘true’ cinnamon (Cinnamomum zeylanicum): A systematic review. BMC Compl. Altern. Med. 2013, 13, 275. [Google Scholar] [CrossRef]
- Soni, N.; Prakash, S. Green Nanoparticles for Mosquito Control. Sci. World J. 2014, 2014, 496362. [Google Scholar] [CrossRef]
- Malheiro, J.F.; Maillard, J.-Y.; Borges, F.; Simões, M. Biocide Potentiation Using Cinnamic Phytochemicals and Derivatives. Molecules 2019, 24, 3918. [Google Scholar] [CrossRef]
- Malheiro, J.F.; Gomes, I.; Borges, A.; Bastos, M.M.S.M.; Maillard, J.Y.; Borges, F.; Simões, M. Phytochemical profiling as a solution to palliate disinfectant limitations. Biofouling 2016, 32, 1007–1016. [Google Scholar] [CrossRef]
- Sova, M. Antioxidant and antimicrobial activities of cinnamic acid derivatives. Mini Rev. Med. Chem. 2012, 12, 749–767. [Google Scholar] [CrossRef]
- Letsididi, K.S.; Lou, Z.; Letsididi, R.; Mohammed, K.; Maguy, B.L. Antimicrobial and antibiofilm effects of trans-cinnamic acid nanoemulsion and its potential application on lettuce. LWT Food. Sci. Technol. 2018, 94, 25–32. [Google Scholar] [CrossRef]
- Anwar, A.; Siddiqui, R.; Shah, M.R.; Khan, N.A. Gold nanoparticle-conjugated cinnamic acid exhibits antiacanthamoebic and antibacterial properties. Antimicrob. Agents Chemother. 2018, 62, e00630-18. [Google Scholar] [CrossRef]
- Rajendran, K.; Anwar, A.; Khan, N.A.; Shah, M.R.; Siddiqui, R. Trans-Cinnamic Acid Conjugated Gold Nanoparticles as Potent Therapeutics against Brain-Eating Amoeba Naegleria fowleri. ACS Chem. Neurosci. 2019, 10, 2692–2696. [Google Scholar] [CrossRef]
- Zhao, Q.; Luan, X.; Zheng, M.; Tian, X.-H.; Zhao, J.; Zhang, W.-D.; Ma, B.-L. Synergistic Mechanisms of Constituents in Herbal Extracts during Intestinal Absorption: Focus on Natural Occurring Nanoparticles. Pharmaceutics 2020, 12, 128. [Google Scholar] [CrossRef]
- Küünal, S.; Rauwel, P.; Rauwel, E. Plant extract mediated synthesis of nanoparticles. In Emerging Applications of Nanoparticles and Architecture Nanostructures: Current Prospects and Future Trends, Micro and Nano Technologies, 1st ed.; Makhlouf, A.S.H., Barhoum, A., Eds.; Elsevier Inc.: Amsterdam, The Netherlands, 2018; Chapter 14; pp. 411–446, eBook ISBN 9780128135167, Paperback ISBN 9780323512541. [Google Scholar]
- Logaranjan, K.; Raiza, A.J.; Gopinath, S.C.B.; Chen, Y.; Pandian, K. Shape- and Size-Controlled Synthesis of Silver Nanoparticles Using Aloe vera Plant Extract and Their Antimicrobial Activity. Nanoscale Res. Lett. 2016, 11, 520–529. [Google Scholar] [CrossRef]
- Bauer, A.W.; Perry, D.M.; Kirby, W.M.M. Single-disk antibiotic-sensitivity testing of staphylococci: An analysis of technique and results. AMA Arch. Intern. Med. 1959, 104, 208–216. [Google Scholar] [CrossRef] [PubMed]
- Clinical and Laboratory Standards Institute (CLSI). Performance Standards for Antimicrobial Disk Susceptibility Testing, 28th ed.; M100S; CLSI: Wayne, PA, USA, 2018; Volume 38. [Google Scholar]
- Khan, A.U.; Khan, M.; Khan, M.M. Antifungal and Antibacterial Assay by Silver Nanoparticles Synthesized from Aqueous Leaf Extract of Trigonella foenum-graecum. BioNanoScience 2019, 9, 597–602. [Google Scholar] [CrossRef]
- Aziz, S.B.; Abdullah, O.G.; Hussein, S.A.; Ahmed, H.M. Effect of PVA Blending on Structural and Ion Transport Properties of CS:AgNt-Based Polymer Electrolyte Membrane. Polymers 2017, 9, 622. [Google Scholar] [CrossRef] [PubMed]
- Brza, M.A.; Aziz, S.B.; Anuar, H.; Al Hazza, M.H.F. From Green Remediation to Polymer Hybrid Fabrication with Improved Optical Band Gaps. Int. J. Mol. Sci. 2019, 20, 3910. [Google Scholar] [CrossRef]
- Al Aboody, M.S. Silver/silver chloride (Ag/AgCl) nanoparticles synthesized from Azadirachta indica lalex and its antibiofilm activity against fluconazole resistant Candida tropicalis. Art. Cells Nanomed. Biotech. 2019, 47, 2107–2113. [Google Scholar] [CrossRef]
- Dhafer, C.E.B.; Dhahri, M.; Mezni, A.; Smiri, L.S.S. Surface - enhanced Raman scattering study of PP/Ag nanocomposite developed to prevent postsurgery infection. J. RAMAN Spectrosc. 2018, 49, 1445–1451. [Google Scholar] [CrossRef]
- Kora, A.J.; Arunachalam, J. Green Fabrication of Silver Nanoparticles by Gum Tragacanth (Astragalus gummifer): A Dual Functional Reductant and Stabilizer. J. Nanomat. 2012, 2012, 869765. [Google Scholar] [CrossRef]
- Malheiro, J.; Maillard, J.; Borges, F.; Simões, M. Evaluation of cinnamaldehyde and cinnamic acid derivatives in microbial growth control. Int. Biodeterior. Biodegrad. 2018, 141, 71–78. [Google Scholar] [CrossRef]
- Hill, L.E.; Gomes, C.; Taylor, T.M. Characterization of beta-cyclodextrin inclusion complexes containing essential oils (trans-cinnamaldehyde, eugenol, cinnamon bark and clove bud extracts) for antimicrobial delivery applications. LWT Food. Sci. Technol. 2013, 51, 86–93. [Google Scholar] [CrossRef]
- De Simone, S.; Gallo, A.L.; Paladini, F.; Sannino, A.; Pollini, M. Development of silver nano-coatings on silk sutures as a novel approach against surgical infections. J. Mater. Sci. Mater. Med. 2014, 25, 2205–2214. [Google Scholar] [CrossRef]
- Blaker, J.J.; Nazhat, S.N.; Boccaccini, A.R. Development and characterisation of silver-doped bioactive glass-coated sutures for tissue engineering and wound healing applications. Biomaterials 2004, 25, 1319–1329. [Google Scholar] [CrossRef] [PubMed]
- Sunitha, S.; Adinarayana, K.; Sravanthi, R.P.; Sonia, G.; Nagarjun, R.; Pankaj, T.; Veerabhadra, S.C.; Sujatha, D. Fabrication of Surgical Sutures Coated with Curcumin Loaded Gold Nanoparticles. Pharm. Anal. Acta 2017, 8, 1–12. [Google Scholar] [CrossRef]
- Ashour, A.A.; Raafat, D.; El-Goweili, H.M.; El-Kamel, A.H. Green synthesis of silver nanoparticles using cranberry powder aqueous extract: Characterization and antimicrobial properties. Int. J. Nanomed. 2015, 10, 7207–7221. [Google Scholar] [CrossRef]
- Wang, L.; Sun, Y.; Che, G.; Li, Z. Self-assembled silver nanoparticle films at an air—Liquid interface and their applications in SERS and electrochemistry. Appl. Surf. Sci. 2011, 257, 7150–7155. [Google Scholar] [CrossRef]
- Sathishkumar, M.; Sneha, K.; Won, S.W.; Cho, C.W.; Kim, S.; Yun, Y.S. Cinnamon zeylanicum bark extract and powder mediated green synthesis of nano-crystalline silver particles and its bactericidal activity. Colloid. Surf. B Biointerface 2009, 73, 332–338. [Google Scholar] [CrossRef] [PubMed]
- Balashanmugam, P.; Kalaichelvan, P.T. Biosynthesis characterization of silver nanoparticles using Cassia roxburghii DC. aqueous extract and coated on cotton cloth for effective antibacterial activity. Int. J. Nanomed. 2015, 1, 87–97. [Google Scholar] [CrossRef] [PubMed]
- Fahmy, H.M.; Mosleh, A.M.; Elghany, A.A.; Shams-Eldin, E.; Abu Serea, E.S.; Ali, S.A.; Shalan, A.E. Coated silver nanoparticles: Synthesis, cytotoxicity, and optical properties. RSC Adv. 2019, 9, 20118–20136. [Google Scholar] [CrossRef]
- Singh, P.; Kim, Y.J.; Wang, C.; Mathiyalagan, R.; Yang, D.C. The development of a green approach for the biosynthesis of silver and gold nanoparticles by using Panax ginseng root extract, and their biological applications. Artif. Cells. Nanomed. Biotechnol. 2016, 44, 1150–1157. [Google Scholar] [CrossRef]
- Kumar, M.; Devi, P.; Kumar, A. Structural analysis of PVP capped silver nanoparticles synthesized at room temperature for optical, electrical and gas sensing properties. J. Mater. Sci. Mater. Elect. 2017, 28, 5014–5020. [Google Scholar] [CrossRef]
- Kirillov, S.A. Novel Approaches in Spectroscopy of Interparticle Interactions, Vibrational Line Profiles and Anomalous Non-Coincidence Effects. In Novel Approaches to the Structure and Dynamics of Liquids: Experiments, Theories and Simulations, 1st ed.; NATO Science Series (Series II: Mathematics, Physics and Chemistry); Samios, J., Durov, V.A., Eds.; Springer: Dortrecht, The Netherlands, 2004; Volume 133, pp. 193–227, ISBN-13 978-1-4020-1847-3. [Google Scholar]
- Aguilar-Hernández, I.; Afseth, N.K.; López-Luke, T.; Contreras-Torres, F.F.; Wold, J.P.; Ornelas-Soto, N. Surface enhanced Raman spectroscopy of phenolic antioxidants: A systematic evaluation of ferulic acid, p-coumaric acid, caffeic acid and sinapic acid. Vibr. Spectr. 2017, 89, 113–122. [Google Scholar] [CrossRef]
- Sahoo, P.K.; Kamal, S.K.; Kumar, T.J.; Sreedhar, B.; Singh, A.K.; Srivastava, S.K. Synthesis of Silver Nanoparticles using Facile Wet Chemical Route. Def. Sci. J. 2009, 59, 447–455. [Google Scholar] [CrossRef]
- Kumar, V.A.; Uchida, T.; Mizuki, T.; Nakajima, Y.; Katsube, Y.; Hanajiri, T.; Maekawa, T. Synthesis of nanoparticles composed of silver and silver chloride for a plasmonic photocatalyst using an extract from a weed Solidago altissima (goldenrod). Adv. Nat. Sci. Nanosci. Nanotechnol. 2016, 7, 015002. [Google Scholar] [CrossRef]
- Hamed, S.M.; Mostafa, A.M.A.; Abdel-Raouf, N.; Ibraheem, I.B.M. Biosynthesis of silver and silver chloride nanoparticles by Parachlorella kessleri SAG 211-11 and evaluation of its nematicidal potential against the root-knot nematode; Meloidogyne incognita. Aust. J. Basic Appl. Sci. 2016, 10, 354–364. [Google Scholar]
- Ellison, J.; Wykoff, G.; Paul, A.; Mohseni, R.; Vasiliev, A. Efficient dispersion of coated silver nanoparticles in the polymer matrix. Colloid. Surf. A. Physicochem. Eng. Asp. 2014, 447, 67–70. [Google Scholar] [CrossRef]
- Bhuiyan, M.A.Q.; Shaifur Rahman, M.D.; Rahaman, M.S.; Shajahan, M.; Dafader, N.C. Improvement of Swelling Behaviour of Poly (Vinyl Pyrrolidone) and Acrylic Acid Blend Hydrogel Prepared By the Application of Gamma Radiation. Org. Chem. Curr. Res. 2015, 4, 2. [Google Scholar] [CrossRef]
- Abdelrazek, E.M.; Abdelghany, A.M.; Badr, S.I.; Morsi, M.A. Structural, optical, morphological and thermal properties of PEO/PVP blend containing different concentrations of biosynthesized Au nanoparticles. J. Mater. Res. Technol. 2018, 7, 419–431. [Google Scholar] [CrossRef]
- Guo, H.; Zhang, Z.; Xing, B.; Mukherjee, A.; Musante, C.; White, J.C.; He, L. Analysis of Silver Nanoparticles in Antimicrobial Products Using Surface-Enhanced Raman Spectroscopy (SERS). Environ. Sci. Technol. 2015, 49, 4317–4324. [Google Scholar] [CrossRef]
- Pilot, R.; Signorini, R.; Durante, C.; Orian, L.; Bhamidipati, M.; Fabris, L. A Review on Surface-Enhanced Raman Scattering. Biosensors 2019, 9, 57. [Google Scholar] [CrossRef]
- Soares, M.R.P.S.; Rafael, O.; Correa, R.O.; Stroppa, P.H.F.; Flavia, C.; Marques, F.C.; Gustavo, F.S.; Andrade, G.F.S.; Correa, C.C.; Brandao, M.A.F.; et al. Biosynthesis of silver nanoparticles using Caesalpinia ferrea (Tul.) Martius extract: Physicochemical characterization, antifungal activity and cytotoxicity. PeerJ 2018, 6, e4361. [Google Scholar] [CrossRef]
- Zhang, Y.; Walkenfort, B.; Yoon, J.H.; Schlucker, S.; Xie, W. Gold and silver nanoparticle monomers are non-SERS-active: A negative experimental study with silica-encapsulated Raman-reporter-coated metal colloids. Phys. Chem. Chem. Phys. 2015, 17, 21120–21126. [Google Scholar] [CrossRef]

| Capping Agent Used | Zeta-Potential (mV) | Particle Size Mean (nm) | Poly-Dispersity Index (PDI) |
|---|---|---|---|
| TCA-AgNP | −17.9 | 61.3 ± 11.2 | 0.390 |
| TCA-AgNP-PI | −33.3 | 57.2 ± 10.4 | 0.464 |
| Cinn-AgNP | −32.9 | 88.1 ± 20.6 | 0.376 |
| Cinn-AgNP-PI | −33.1 | 51.5 ± 7.8 | 0.486 |
| Strain | Anti-Biotic | A | 1W | 2W | 3W | 4W | 1D | 2D | 3D | 4D | 1D* | 2D* | 3D* | 4D* |
|---|---|---|---|---|---|---|---|---|---|---|---|---|---|---|
| S. pneumoniae ATCC 49619 | G | 21 | 16 | 17 | 0 | 0 | 14 | 13 | 0 | 13 | 10 | 10 | 0 | 0 |
| S. aureus ATCC 25923 | G | 27 | 17 | 21 | 14 | 20 | 16 | 15 | 10 | 13 | 14 | 10 | 9 | 12 |
| E. faecalis ATCC 29212 | CTX | 25 | 13 | 15 | 10 | 11 | 12 | 12 | 0 | 12 | 9 | 0 | 0 | 0 |
| P. aeruginosa WDCM 00026 | CTX | 20 | 20 | 27 | 15 | 15 | 20 | 20 | 10 | 14 | 13 | 13 | 0 | 11 |
| E. coli WDCM 00013 | G | 23 | 17 | 17 | 14 | 14 | 17 | 18 | 11 | 12 | 13 | 13 | 10 | 10 |
| C. albicans WDCM 00054 | NY | 16 | 18 | 13 | 0 | 15 | 13 | 0 | 0 | 0 | 10 | 0 | 0 | 0 |
| Strain | Anti-Biotic | A | 1S | 2S | 3S | 4S |
|---|---|---|---|---|---|---|
| S. pneumoniae ATCC 49619 | G | 21 | 0 | 0 | 4 | 0 |
| S. aureus ATCC 25923 | G | 27 | 1 | 5 | 1 | 1 |
| E. faecalis ATCC 29212 | CT | 25 | 0 | 0 | 0 | 0 |
| S. pyogenes ATCC 19615 | C | 25 | 2 | 2.5 | 0.5 | 0 |
| B. subtilis | S | 20 | 4 | 5 | 0 | 0 |
| P. aeruginosa WDCM 00026 | CTX | 20 | 5 | 5 | 3 | 1 |
| E. coli WDCM 00013 | G | 23 | 5 | 5 | 0 | 4 |
| K. pneumoniae WDCM 00097 | CTX | 35 | 4 | 5 | 5 | 1 |
| P. mirabilis ATCC 29906 | G | 35 | 1 | 1 | 0 | 1 |
| C. albicans WDCM 00054 | NY | 16 | 0 | 0 | 0 | 0 |
© 2020 by the authors. Licensee MDPI, Basel, Switzerland. This article is an open access article distributed under the terms and conditions of the Creative Commons Attribution (CC BY) license (http://creativecommons.org/licenses/by/4.0/).
Share and Cite
Edis, Z.; Haj Bloukh, S.; Ibrahim, M.R.; Abu Sara, H. “Smart” Antimicrobial Nanocomplexes with Potential to Decrease Surgical Site Infections (SSI). Pharmaceutics 2020, 12, 361. https://doi.org/10.3390/pharmaceutics12040361
Edis Z, Haj Bloukh S, Ibrahim MR, Abu Sara H. “Smart” Antimicrobial Nanocomplexes with Potential to Decrease Surgical Site Infections (SSI). Pharmaceutics. 2020; 12(4):361. https://doi.org/10.3390/pharmaceutics12040361
Chicago/Turabian StyleEdis, Zehra, Samir Haj Bloukh, May Reda Ibrahim, and Hamed Abu Sara. 2020. "“Smart” Antimicrobial Nanocomplexes with Potential to Decrease Surgical Site Infections (SSI)" Pharmaceutics 12, no. 4: 361. https://doi.org/10.3390/pharmaceutics12040361
APA StyleEdis, Z., Haj Bloukh, S., Ibrahim, M. R., & Abu Sara, H. (2020). “Smart” Antimicrobial Nanocomplexes with Potential to Decrease Surgical Site Infections (SSI). Pharmaceutics, 12(4), 361. https://doi.org/10.3390/pharmaceutics12040361








